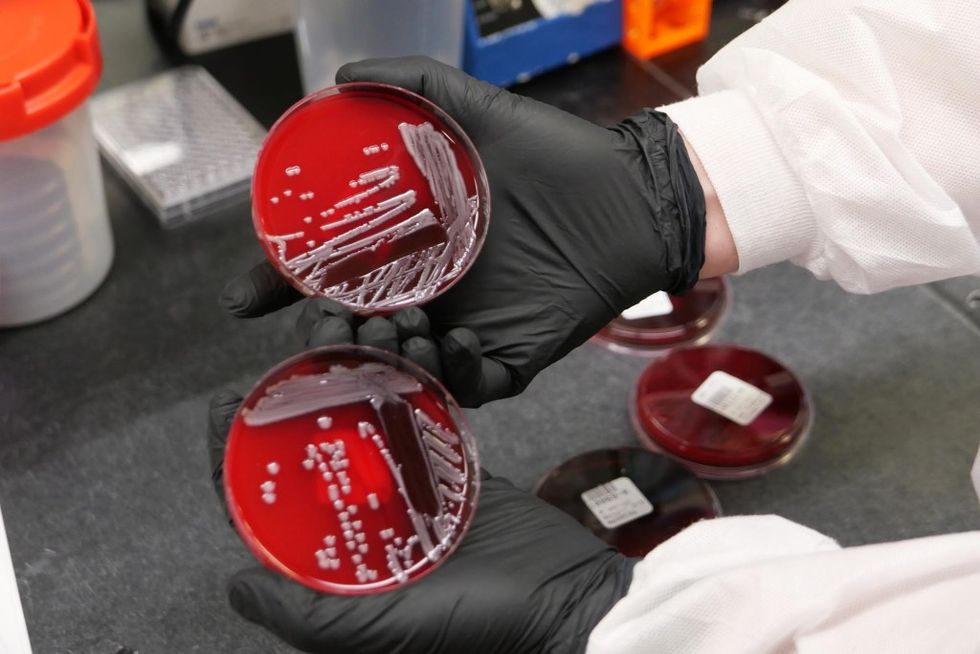

When Sergiy Antonenko came to, he was on fire.
As he regained consciousness, the Ukrainian sniper realized the blaze set off by the makeshift explosive was all around him. It took nearly every remaining ounce of energy he had to roll into the river abutting the nameless village at the Dnipro border where his brigade had held the line against the Russians. When Antonenko woke up two and a half weeks later, in September 2022, he was in a hospital bed in Kyiv. He had suffered third-degree burns over 25 percent of his body.
In the ensuing months, Antonenko’s injuries became a nightmare. The former farmer had lived through the battle, but his larger war for survival was just beginning. And it was taking place on a microscopic scale.
Purplish, red-speckled burns now lined Antonenko’s arms, legs, torso, and back like odd, geometric tattoos. Where the burns came, the bacteria followed. In his case, a species of Klebsiella so vicious that no antibiotic in modern medicine’s arsenal could stop it from feasting on his flesh, entering his bloodstream, and throwing the then-28-year-old into life-threatening sepsis.
Antonenko’s case is far from rare. Injured soldiers all over the world are increasingly fighting a deadly, invisible enemy: drug-resistant bacteria, or so-called superbugs, which can spread like wildfire in conflict zones. But the risk is not limited to soldiers alone. As conflicts proliferate in all corners of the globe — Gaza, Yemen, Ecuador, Haiti — doctors are increasingly worried that the superbugs will find their way into civilian populations, too.

The problem first came to light during the American invasion of Iraq in 2003. At the time, Marines were surviving Humvee explosions and shrapnel injuries overseas only to die later of superbug infections back home. Since then, nearly two decades of research shows that the superbug threat isn’t just the stuff of off-tour veteran rumor mills.
In 2019, the Centers for Disease Control and Prevention (CDC) put out a most wanted list of 18 different bugs — technically, antimicrobial-resistant organisms, or AMRs for short — that the agency called “one of our greatest public health concerns.” The report cited nearly three million drug-resistant infections per year in the U.S. — and enough deaths annually to fill Madison Square Garden two-and-a-half times over.
Moreover, as hospitals were overwhelmed by surges of Covid patients, the pandemic reversed the historical progress in the fight against superbugs: Infection rates — and deaths — each leapt 15 percent in the first year of the pandemic alone, a 2022 CDC report found. (An update released by the CDC on July 16 showed persistence of these trends: “We can and must do more to combat antimicrobial resistance,” the agency wrote in a press release.) Globally, AMRs are estimated to contribute to five million deaths every year — a number larger than the entire population of Croatia, and greater than deaths from HIV and malaria combined.
The science also shows that the problem is worse than it’s ever been. In the time since Marines started dying from sepsis on American soil, epidemiologists have learned of the potential for military conflict to amplify the transmission of superbugs. Research indicates that as the detritus of war — warheads, spent munitions, and the wreckage of pummeled cities — drains into surrounding waterways, it creates heavy-metal-infused cesspools in which AMRs thrive.
Meanwhile, within hospitals in bloodied countries, superbugs are jumping from soldiers injured in the field to civilians receiving care for conditions entirely unrelated to the war. That means citizens in places already least equipped to respond to health crises, like Ukraine or Gaza — where doctors on the ground were already documenting the spread of superbugs one month after Hamas’ October 7th attack — are facing still-more-brooding threats due to AMRs. And as refugees flee war-torn countries, those organisms may be on the move, too.
According to Arkadii Vodianyk, the World Health Organization’s AMR lead in Ukraine, the effect of that conflict on the spread of superbugs is already apparent. “The map — it looks terrible,” Vodianyk says. “We suspect the impact will be very big.”
Despite the looming threat, so far, efforts to combat AMRs both domestically and abroad have largely fallen flat. In the two decades since U.S. military doctors saw superbugs in returning vets — and in the decade since the CDC first described the urgent need to confront the issue — governments around the world have failed to make superbug prevention a priority compared with addressing other, often more visible problems, experts say.
In that way, AMR has become the climate change of medicine. It’s a slow-brewing catastrophe: an inch of sea-level rise here, an extra nursing home death there. And the mundane steps needed to extinguish it — say, shipping millions of petri dishes to conflict zones and training scientists in basements an ocean away how to use them — rarely get politicians elected compared with sending Abrams tanks or Tomahawk missiles.
Those failures have people like Charles Vitek, the CDC’s regional director for Eastern Europe and Central Asia, concerned. Since the Russia-Ukraine war broke out in February 2022, he’s watched as AMR levels in his region have “exploded.” Which is part of the reason, last December, Vitek’s team pushed out a paper to sound the alarm. They found that bacteria resistant to some of the heaviest-hitting drugs available were 10 times more common in Ukraine than in the European Union.
The proliferation of AMRs across his region is a microcosm of a bigger issue that worries Vitek most: the potential for international spread that can set the stage for a pandemic.
“Pandemics come in different sizes and speeds,” Vitek tells Rolling Stone, comparing AMR to the Covid crisis. “It’s just that this one’s happening at a different speed.”
ON THURSDAY NIGHTS in Jamestown, South Carolina, the Gadsden family would gather for scripture. Of all her kids, Zeada Gadsden-Morris says Jonathan — the fifth of seven — was the most spiritual. A reserved bookworm who adored history almost as much as his mom’s cooking, Jonathan would open up when it came to Revelations. He’d ask questions late into the night, Gadsden-Morris says, as his siblings begged to go to bed.

So, when Jonathan decided to take up the family tradition and join the Marines, Gadsden-Morris was surprised. Still, she was supportive from the outset, forever a phone call away when sergeants busted his ass during conditioning drills, or when comrades busted his chops for moisturizing his legs in the shower. She was no less supportive when he told her he was headed to Iraq the first time in 2002, or the second time in 2004. She was no less supportive when he returned after an IED had blown up his Humvee and killed his fellow soldiers, rendering him comatose and unrecognizable.
Over the next month, she sat by Jonathan’s bedside every day. Gadsden-Morris remembers the first day he responded to her voice, the first day he ate, the first day he walked, the first day they took him off antibiotics. She also remembers seeing the crash cart in front of his room on the morning he seized after the bacterial infection spread to his brain. And she remembers when, at 2:15 a.m. on an October Friday in 2004, they took him off the ventilator. “He didn’t last five minutes,” Gadsden-Morris says.
Jonathan, like Antonenko decades later, had survived the battle. But he didn’t survive the war.
Gadsden-Morris was told one bacteria in particular was responsible for her son’s death: an organism called Acinetobacter. She couldn’t even pronounce it at first, she recalls. In fact, she still can’t.
The organism surprised the experts, too. Acinetobacter “was not on my radar at all,” Jerome Herbers, an Army physician and public health specialist who was involved with Jonathan Gadsden’s case, tells Rolling Stone. He’d never seen it on America’s home turf; his experience with the bug was limited to soldiers who “developed illnesses in faraway places,” he says.
Perhaps as a result, “Acinetobacter was not on the lips of the people at Bethesda [either],” Herbers adds, referring to the medical team at the National Naval Medical Center in Maryland, where Gadsden stayed for much of his care.
A 2019 CDC report cites three million drug-resistant infections per year in the U.S. — and enough deaths annually to fill Madison Square Garden two-and-a-half times over.
Though the superbug may not have been top of mind for doctors at the time, subsequent research shows it was all over the U.S. More than 100 Acinetobacter cases were reported in U.S. soldiers across the globe in the first two years of the Iraq War, according to a CDC report released shortly after Gadsden’s death. “Because the organism has developed substantial antimicrobial resistance,” the authors wrote, “treatment of infections attributed to [Acinetobacter] has become increasingly difficult.”
Only years later, when a 2008 PBS documentary narrated by Neil deGrasse Tyson described “a new enemy invader emerging from Iraq…[able to] survive weeks at a time without food or water” did the bug enter the collective American consciousness. After tearing through hospitals in Iraq, it was entering the U.S. by hitching a ride on returning soldiers, Tyson said, and it was spreading — fast.
Accordingly, the supervillain received a new alias: “Iraqibacter.”
THE TENTS AT the 28th Combat Support Hospital at Camp Dogwood outside of Baghdad were pegged into the dirt and zipped together, thick ropes coiling madly about. Narrow corridors ran between cordoned-off rooms, forming a maze in the sand. And soon after Richard Teff arrived in the winter of 2003, the patients started pouring in.
The injuries suffered by American soldiers at the Iraqi frontlines were almost all the same in nature, Teff says: penetrating wounds from makeshift explosives, shrapnel buried deep into faces and scalps. These types of wounds are grossly contaminated, chock full of bacteria from the soil, from the shredded camo uniform, from the soldier’s own skin. The incineration of flesh creates temporary vacuums that suck in even more bacteria.
In the 90-degree heat, peering through dust that enveloped their makeshift operating rooms, the Army neurosurgeon’s team would drill into soldiers’ skulls. Using surgical lamps powered by intermittently functional generators to illuminate glass and soil and blood and brains, they’d look around. They did what they could, Teff says: evacuate this clot, extract that fragment, or cauterize the other vessel. But so many of these injuries entailed a complicated calculus when it came to treatment. Often, that meant doing less surgery rather than more, since removing every last shard of shrapnel is some combination of impossible, impractical, and risky.
“You’d basically wash out what you could,” Teff says, “but you weren’t going to go digging for [shrapnel] or take a lobe out of somebody’s head trying to get it out.” If an infection were to develop, he adds, the thinking was “you can deal with that later.”
But 6,200 miles west, those infections were quickly becoming more than an afterthought for Army physician Emil Lesho. Midway through his infectious disease training at Walter Reed Hospital, the Army’s flagship medical center, in Bethesda, he was seeing tons of Acinetobacter infections firsthand — infections that were invariably frustrating. “It would get resistant to this antibiotic, then it would get resistant to that antibiotic,” Lesho says. “We were chasing our tails.”
The general sentiment was that this thing seemed to have come out of nowhere. “Prior to that, in the military, Acinetobacter wasn’t a big thing; it wasn’t common,” Lesho says. “Or, we just didn’t know about it.”
Partly, that’s due to Acinetobacter’s evasive nature. The bacteria is notoriously difficult to pin down, Patrick McGann, a microbiologist at the Walter Reed Army Institute of Research, tells Rolling Stone. It’s inherently shape-shifting, depending on the time and place: Examined under a microscope it sometimes looks a rod, sometimes a circle; sometimes like one bug, sometimes like another. (Gadsden’s Acinetobacter, for example, had initially been classified as Nocardia, an altogether separate organism.)
The other part of the challenge is a systems one: In the early days, there was no way for doctors to enter Acinetobacter into soldiers’ medical records that would allow them to count the cases. As such, what epidemiologists call “attributable mortality” — or, the number of soldiers who died from the bug — remained largely unknowable, Lesho says.
Aware of those headwinds, Lesho lobbied for increased monitoring — soldiers were dying, he reasoned with superiors, and the media “was asking questions we honestly could not answer” about infection rates and death counts. Those conversations, though, often turned circular. “The generals and the funding guys would ask us the same question — how many guys did Acinetobacter kill? And you couldn’t say,” Lesho recalls.
So, priorities remained elsewhere. “They’d say, ‘Go away, I have bigger problems,’” Lesho says. “Military folks — they’re all focused on beans and bullets and shit.”
Still, the question possessed him: Where were the superbugs coming from?
IN FEBRUARY 2022, as missile strikes rained down on Kharkiv and Cherkasy, Oleg Chapailo and his only son watched Telegram videos of the assault in horror. By evening, the young man — who had recently turned 18 years old — asked his dad to bring him to the Ukrainian draft office in their hometown of Slavuta. “No,” Chapailo said. “Me first.”
The next day, Chapailo set out east towards the Russian border. He spent the next six months planting mines under bridges, excavating trenches, and digging foxholes from Dnipro to Donetsk.
On September 18, Chapailo’s unit was driving — allied helicopters roaring overhead — when an explosion rocked their truck. He was thrown to the ground and scurried to reorient himself. We’re under attack, he thought. He took stock of the situation minutes later, only then realizing he “was not whole.” His hands, his feet, his face — the flesh was all charred. Then, the pain. “It’s not realistic to try to explain it in words,” he recalled to me months later.
Chapailo was raced west: a MASH hospital miles away, Zaporizhzhia, Dnipro, Kyiv, and, ultimately, Brussels. His memory is blurry, he says, but what he does remember was “hell on earth.” The dressing changes were the worst.
What he doesn’t remember, though, is the thing that almost killed him: Klebsiella.
In the years after the Red Army’s invasion in 2014, AMRs like Chapailo’s strain of Klebsiella became commonplace. In 2022, one Lviv hospital reported that the vast majority of patients had AMRs. Other studies from Ukrainian military hospitals have since found rates of drug resistance in Klebsiella, Acinetobacter, Pseudomonas, and other species far exceeding those in other countries. A May 2024 study also found that, as the conflict has pushed on, laboratory capacity at hospitals facing an “unprecedented influx” of war-wounded has significantly decreased — suggesting that whatever figures do exist likely undercount the true burden of AMR.
AMR has become the climate change of medicine: It’s a slow-brewing catastrophe.
At Khmelnytskyi City Hospital — the western Ukrainian city’s major facility — the problem had been present and worsening for years, according to Andrii Makogonskyi, an emergency medicine doctor and co-director of the hospital’s infection prevention committee. The burden of superbugs was particularly obvious in the intensive care unit: “These patients would come in looking like any other,” he says, until “we started to see the resistance emerge.” Klebsiella resistance at the hospital to the heaviest-hitting, last-ditch medications is four times higher than global rates.
In Khmelnytskyi, like elsewhere across Ukraine, the AMR problem has only intensified since February 2022, Makogonskyi says. Data obtained by Rolling Stone from the Ukrainian Ministry of Health show other species — like E. Coli — also had resistance rates to powerful antibiotics that were up to 2.5 times higher in Ukraine than globally. And in December, the CDC report put out by Vitek’s team confirmed these findings: AMR rates — including to last-ditch antibiotics — were “substantially higher” in Ukraine than those across Europe.

“If this was a problem before the war,” Makogonskyi says, “now, with the conflict, it’s even worse.”
FOR SERGIY BORODAVKO, a trauma surgeon in Kyiv who’d previously been dispatched to frontline hospitals at Bakhmut and Zaporizhzhia, the explanation for the surge of AMRs seems straightforward: battle. Mines, mortar, missiles — they all result in innumerable metal fragments, bathed in bacteria-laden mud and muck, implanting in the body.
But, as with Teff’s experience in Iraq, in the initial phases of frontline treatment, the focus is always on stabilization rather than sterilization, Borodavko says. In other words: Keep the soldiers alive. “The question is never how much can you take out,” Borodavko says, “it’s how much can you leave in.”
As a result, wounded soldiers go for long periods with contaminated metal buried within them. Bacteria can colonize the shrapnel, forming microscopic sleeper cells in which they can survive for weeks or months. You can see and feel these colonies when snipping through fat and dissecting around muscle in the operating room, Borodavko says: Often, scar-like tissue can form around the shrapnel to wall off the bacteria from the rest of the body.
All the while — during those quiet weeks and months of recuperation, of movements from one hospital to the next — soldiers are shedding superbugs. Onto other soldiers during mass casualty events at MASH hospitals. Onto truck beds in transit to city centers. Onto beds, floors, and ceilings of their hospital rooms. Onto cargo holds of the aircraft evacuating them to acute care centers in other countries. Onto healthcare staff in every one of these places, who can spread the organisms to other patients, or get infected themselves.
It’s when those sleeper cells access blood vessels — or, when they themselves are disrupted, such as by hacking through them intraoperatively months later during a reconstructive surgery — that the bacteria can transition from defensive to offensive, pouring into the bloodstream, infecting distant organs, and pumping out the kinds of toxins that cause plummeting blood pressures and shock. “The bacteria are sleeping,” Borodavko says, “and only after [a] surgery, they wake up.”
Makogonskyi, the emergency-medicine doctor in Khmelnytskyi, has seen a similar story play out over and over. “By the time they get to the hospital,” he says, “there’s not that much doctors can do.“ Infectious control, he adds, works better when it starts at the frontline, but that’s a tall task: At the front, ”we have many blunders when it comes to preventing infections.“

Of course, it’s not just the soldiers who suffer these infections: On every ward of Khmelnytskyi City Hospital, civilians — who comprise 70 percent of the hospital’s patients — have been infected by AMRs first isolated in soldiers, according to Makogonskyi. “AMR is the price we pay,” he says, “for saving the lives of our soldiers.”
DISCOVERING THE ORIGIN of superbugs in war zones isn’t just about individual amputees or burn victims. It’s also about how war disfigures a country’s landscape.
Omar Dewachi witnessed it firsthand in Baghdad. He was a senior in high school when America launched Operation Desert Storm. Over the next six weeks, the U.S. dropped nearly 90,000 tons of bombs over Baghdad. Heaps of rubble accumulated that would take months to clear, and plumes of smoke filled the skies.
Still, Dewachi, who is now a doctor and associate professor of global health at Rutgers University, didn’t truly appreciate what he calls the “ecology of war” until years later. As ammunition, bombs, and the guts of buildings spill into a country’s ponds and rivers, the land itself becomes an open wound, Dewachi says. Research has found the decimation of natural forests and riverbanks leads to accelerated erosion, spilling soil infused with heavy metals from munitions and debris into the waterways. That kind of contamination can last for decades, research shows. For example, Belgian soil samples taken in 2008 demonstrated elevated levels of copper, lead, and zinc 90 years after World War I raged in the region. In the ecological sense, “[you are] dealing with a wound that doesn’t heal,” Dewachi says.
Environments completely disrupted by heavy-metal contamination can be as much a primordial soup for incubating drug resistance as the shrapnel wound itself, Muhammad Zaman, a biomedical engineer at Boston University, says. Studies show that higher levels of environmental metal can actually stimulate bacteria like Acinetobacter. And since heavy metals are one of nature’s original antibiotics, traits protecting bacteria against antibiotics can live right next to ones that help them survive metal on the bacterial genome. In other words, the same genetic light switch that turns on metal resistance also activates antibiotic resistance.
To Zaman, understanding where superbugs come from means looking at the whole environment where they proliferate rather than looking solely at individual injured soldiers. In that way, AMR driven by war-related environmental change can “become basically native” to conflict zones, Zaman says.
Put differently, the threat doesn’t end when a ceasefire is called. “Those corpses in those charred buildings are not just affecting people now,” he says. “They’re probably going to affect people for a long time to come.”
FOR NEARLY TWO decades, Ezra Barzilay, a pediatrician by training who now directs the CDC’s office in Kyiv, has been charged with making sure superbugs that start in war-ravaged places don’t find their way home to the U.S. Once upon a time, it was mainly HIV that kept him up at night. But now, it seems, every year, the list of superbugs is growing longer. Since the war in Ukraine began, Barzilay has watched organisms like Klebsiella and Acinetobacter emerge in force.
As an injured soldier or a refugee is moved from one place to the next, “those are opportunities for transmission,” Barzilay says. “In the time of modernization and travel, diseases don’t have boundaries.”
According to data obtained by Rolling Stone from the European Commission’s Emergency Response Coordination Centre, as of January 2023, more than 1,700 Ukrainians had been evacuated to 18 European countries for medical care. About 500 traveled to two or more countries during their care. Already, nations including Germany, England, and the Netherlands have documented the presence of war-derived AMRs — superbugs with drug resistance far exceeding native levels — in their hospitals. Taken together, these patterns have put the European CDC (ECDC) on high alert.
“What we see, in terms of drug-resistant infections, is very conspicuously related to those who were transferred from Ukrainian hospitals,” Diamantis Plachouras, lead of the ECDC’s healthcare associated infections group, says.
Moreover, Plachouras worries that the implications stretch beyond hospitals. Another concern for him is nursing homes, whose residents frequently bounce back and forth between the hospital for care. Plachouras says he can imagine a situation where “they go to the hospital, they get a drug-resistant infection, and then, when they [return], they are the source of spread to other members of the community.” In that scenario, Plachouras adds, “[AMR is] a problem for millions of people.”
“Those corpses in those charred buildings are not just affecting people now. They’re going to affect people for a long time to come.”
Muhammad Zaman, biomedical engineer at Boston University
If Ukraine’s recent bid to join the EU succeeds — making migration even easier between the nation and the bloc — the problem could get even worse.
The EU has not been standing idly by. Since 2017, the WHO — fueled by EU money — has been hustling to increase Ukraine’s capacity to detect, track, and treat superbugs. They’ve already sent thousands of test kits to dozens of labs across the country, the WHO’s Vodianyk says.
In the past year though, they’ve been losing the battle. A pilot study conducted by the WHO showed that the burden of AMRs almost tripled since February 2022 — a figure that could be even higher, as much of the country still lacks the ability to routinely detect AMRs, and Ukraine’s military hasn’t shared statistics on casualty counts, Vodianyk says.
Meanwhile, the war pushes into its third year, and the cycle of destruction and infection continues.
These days, Oleg Chapailo is living at a rehabilitation facility near Lviv, close to the Polish border, slowly but surely working his way back to full health. Every now and then, he’s able to go home, to live out what he’s been daydreaming about since his hospital stay in Brussels: a shashlik overlooking the lake abutting his backyard, roasting pig over the open fire, sipping an ice cold Slavutych beer.
Still, Chapailo plans to re-enter the military service as soon as he’s able. “I am built for the frontline,” he says. “I could be put to better use there than here.”
Antonenko, for his part, is now back in Dnipropetrovsk, in the eastern part of the country. After returning home, he fulfilled a promise to himself: to visit the tombstones of his fallen comrades — including his friend with whom he originally enrolled in the military. Antonenko was discharged from service due to the extent of his injuries, which have left him scarcely able to walk. He doesn’t know how his future — or the future of his country — will look.
To Vodianyk, as long as the conflict endures, one outcome is certain: AMRs will continue to spread. As such, the WHO’s strategy has pivoted. For now, they’re not focused on “turning things around,” Vodianyk says. Instead, the priority is “damage control.”
BACK IN THE U.S., Emil Lesho’s dream to improve the monitoring of superbugs eventually did come true: Since 2009, the Army has supported a surveillance network — a microbiological CIA, of sorts — to track the highest-threat AMRs across the world. Patrick McGann, the Walter Reed microbiologist, is now the network’s deputy director, a role which has him alternately throwing on a white coat to pipette clear liquids into fogged vials and donning a suit to lecture from coast to coast. But, since February 2022, McGann’s team has faced similar obstacles to Vodianyk’s, limiting the organization’s ability to track the development of AMRs in Ukraine.

At the same time, the Department of Defense has appeared not to implement any new protocols or initiatives to prevent the spread of AMR during the war, including sending diagnostics (like genome sequencing tools), therapeutics (amid global antibiotics shortages caused, in part, by supply chains disrupted due to the war), or personnel (like epidemiologists or bioinformaticians) to support Ukrainian surveillance and treatment. In contrast, as of May 9, the U.S. had provided nearly $175 billion in tanks, bullets, howitzers, and other military aid to Ukraine. (The Department of Defense did not respond to multiple requests for comment.)
Domestic efforts to combat AMR have stalled, too. The PASTEUR Act, designed to target “the most challenging pathogens and most threatening infections,” has been mired in Congress for two and a half years, a casualty of political polarization and the chamber’s years-long stalemate. In April, a bipartisan coalition reintroduced the bill for a third cycle. “America can’t afford to be asleep at the wheel when it comes to the threat of antimicrobial resistance,” Jake LaTurner (R-Kan.), said in a statement supporting the legislation.
The stalemate has left people like Zeada Gadsden-Morris frustrated that her son died in vain. And it leaves them concerned that, as the never-wars continue to smolder across the globe, it’s only a matter of time until increasingly endemic superbugs abroad come home to roost.
Should Gadsden-Morris have the opportunity to testify in Congress, she knows what she’d ask: “How much do you care about those guys who go and fight?”
And, she’d add, “if this thing starts spreading — not only to the military, but to the normal people, then what are you going to do?”














War Is Peace: Trump’s Regime-Change Reversal
As American and Israeli rockets fly into Tehran, with the stated goal of regime change, anyone who bought into the self-evidently absurd idea of “Donald the Dove” ending America’s forever wars ought to be suffering from a bloody form of buyer’s remorse.
It was always bullshit. But that’s what the Trump team was selling hard. Take human ghoul Stephen Miller’s tweet days before the election: “Kamala = WWIII. Trump = Peace.”
The Trump team reads George Orwell’s 1984 like an owner’s manual and so of course “war is peace.” Their undermining of NATO and the dismantling of American alliances in favor of a “might makes right” foreign policy executed by a sycophantic kakistocracy is a guarantee of more war amid autocratic power grabs worldwide, with a side order of corrupt crony capitalism to profit from the chaos.
If you voted for Trump and believed him, this is on you. And that includes self-styled Palestinian peace activists who thought that Biden and Harris were the worst of all possible worlds and stayed home. We will no doubt see protests for the innocent lives lost in these strikes — but I’d have a lot more time for those folks if they were also seen protesting the estimated 20,000 to 30,000 Iranian lives snuffed out by murderous mullahs in the last few months alone.
The Islamic Republic of Iran has been despotic and dangerous from its inception. The Iranian people have been oppressed and denied basic freedoms for decades. But this is an extreme example of a war of choice. The American military strikes against Iran’s nuclear weapons facility last year were justified because Iran cannot be trusted with a nuclear weapon. That is true. But the much trumpeted total obliteration of those facilities is apparently not true — or so goes the justification for this war. And don’t forget that it was Trump who pulled the U.S. out of an Obama-era deal to stop Iran from developing weapons — arguing absurdly that the imperfect anti-nuke deal needed to be blown up to stop Iran from developing a bomb. Iran’s subsequent progress toward a bomb then created the rationale toward these strikes. This is a self-inflicted state of emergency. Peace is war and war is peace.
Pity the willful dupes in Congress who deluded themselves into thinking that Trump deserved the Nobel Peace Prize. They’ll probably rationalize that he would’ve been peaceful if he got the honor. Now it will be read as a cautionary tale for not sucking up. The chairman of the Board of Peace is now bored of peace. While Rand Paul remains admirably consistent, it’s Lindsey Graham who is pirouetting around the Senate floor while the Gimp Speaker Mike Johnson is unable to speak for the basic constitutional principles of separation of powers let alone authorization to go to war.
If you’re feeling shell-shocked trying to keep up with Operation Epstein Distraction, get ready for the inevitable next crisis — regime change without a plan for replacement. This is what the Trump administration did in Venezuela — kidnapping the socialist dictator Maduro but keeping his regime in place in exchange for crude oil access. The opposition is still in exile and its leader María Corina Machado gave her Nobel Peace Prize to Trump in exchange for exactly nothing.
One of the clear lessons of history is that if you don’t win the peace, you don’t win the war. The Saudis and their Sunni allies will back the U.S. and Iran because they hate the Shia Iranians (who, incidentally, are not Arabs), but beyond removing the Iranian regime, the plans for replacement and stabilization seem TBD — and with Trump’s inability to stay focused on anything beyond his immediate self-interest, solid plans are unlikely to emerge. Maybe a leader will come from the underground opposition; maybe it will be the Shah’s son, who has been living in the U.S. waiting for a restoration like many members of the diaspora. The upside is that Iran has a distinguished history and an accomplished Persian culture: The Islamists don’t represent the entirety of the people of Iran and never have.
But the path ahead will be messy at best. It will require concerted effort and civil commitment, not just an open call for private investment from Mar-a-Lago members. If the United States is now kidnapping and killing dictators without direct provocation, it establishes a dangerous precedent which will come back to bite us after demolishing our moral authority in the world.
It is the unexpected effects, the cascades of consequence where we cannot always plan ahead, that cause most responsible statesmen to try to keep the peace. But Trump has the carelessness of a rich-boy bully who can always buy or bluster his way out of trouble. He’s a con man who has found his ultimate mark in his followers, who fool themselves into thinking that a reflexive liar is the one man with the courage to tell the truth.
Perhaps the most prominent example is the vice president himself — a bright guy who not that long ago compared Trump to Hitler and a deadly narcotic but then convinced himself that careerism demanded an abrupt conversion. After all, he endorsed Trump less than two years ago with this very serious column headlined “Trump’s Best Foreign Policy? Not Starting Any Wars,” explaining, “He has my support in 2024 because I know he won’t recklessly send Americans to fight overseas.”